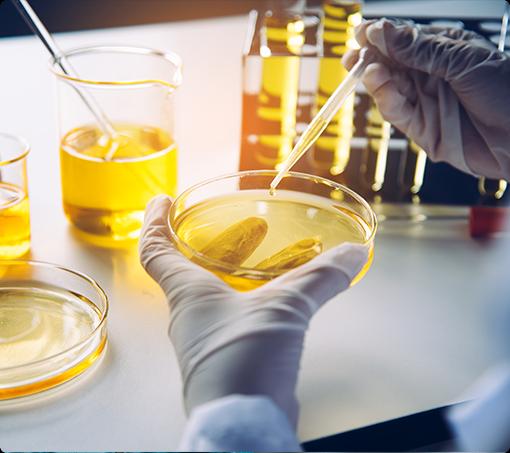

Press release
Project Report on Ethylene Dibromide Manufacturing Plant: Business Strategy, Equipment Needs, and Cost Breakdown
Syndicated Analytics' latest report, titled "Ethylene Dibromide Manufacturing Plant Project Report: Industry Trends, Manufacturing Process, Plant Setup, Machinery, Raw Materials, Investment Opportunities, Cost and Revenue (2023 Edition)," provides comprehensive insights for establishing an ethylene dibromide manufacturing plant. The report covers industry performance, key success factors, risk factors, manufacturing requirements, project costs and economics, expected ROI, and profit margins. It combines desk research and qualitative primary research, making it an essential resource for entrepreneurs, investors, researchers, consultants, and business strategists planning to enter the ethylene-dibromide industry.Ethylene Dibromide Manufacturing Plant:
Ethylene dibromide (C2H4Br2), also known as 1,2-dibromoethane, is a colorless, heavy synthetic liquid with a sweet, chloroform-like odor. It is produced through the reaction of ethylene gas with bromine. Ethylene dibromide exhibits various properties, such as its highly volatile nature and excellent solubility in organic solvents. It is widely used as a fumigant for grains, intermediate in organic synthesis, and solvent for waxes and oils. It is also used in the textile industry, termite treatment, and certain pharmaceutical preparations. Ethylene dibromide offers multiple benefits, such as high reactivity, low cost, and ease of application. It also provides numerous advantages, such as quick evaporation, high penetration capacity, broad-spectrum efficacy against pests, and long shelf life.
Request for a sample report or buy full report: https://www.syndicatedanalytics.com/request?type=report&id=1926&flag=B
Trends and Drivers:
The widespread product utilization in the agricultural sector as a fumigant for stored grains is propelling market growth. Along with this, the growing product demand to control a broad spectrum of pests in farming applications is acting as another growth-inducing factor. Besides this, the increasing product utilization in food preservation techniques to combat spoilage and loss is supporting the market growth.
Furthermore, the rising product adoption as an intermediate in the production of agrochemicals and pharmaceuticals is contributing to the market growth. Additionally, the recent technological advancements in the chemical industry, such as the integration of automation and control systems in manufacturing processes that are streamlining the production of Ethylene Dibromide, thus reducing costs and enhancing quality, are favoring the market growth. Moreover, the increasing product utilization as an additive in the petrochemical industry is strengthening the market growth.
Report Coverage: The project report includes the following information
Market Overview:
Market Performance
Regional Insights
Key Market Segmentation
Price Trend Analysis
COVID-19 Impact
Market Outlook
Market Key Players Analysis
Manufacturing Operations:
Product Description and Insights
Detailed Process Flow
Identification of Unit Operations Involved
Mass Balance Analysis and Raw Material Requirements
Quality Control
Project Requirements, Details, and Costs:
Site Development, Location, and Land Requirements
Plant Layout
Machinery Requirements and Associated Costs
Raw Material Requirements and Associated Costs
Packaging Requirements and Associated Costs
Transportation Requirements and Associated Costs
Utility Requirements and Associated Costs
Manpower Requirements and Associated Costs
Project Financial Analysis:
Capital Investments Analysis
Operating Costs Analysis
Expenditure Projections Analysis
Revenue Projections Analysis
Taxation and Depreciation Analysis
Profit Projections Analysis
Comprehensive Financial Analysis
Ask the Analyst for Customization and Explore Full Report With Table of Contents: https://www.syndicatedanalytics.com/request?type=report&id=1926&flag=C
Need Customized Project Report?
You can share any particular business requirements that you have, and we will adjust the scope of the report to your needs. The following are some typical customizations that our clients ask for:
The report may be customized based on the region/country in which you intend to locate your business.
The production capacity of the facility can be customized in accordance with your needs.
Suppliers of machinery and prices can be tailored to your requirements.
Depending on your needs, we may also modify the current scope.
Key Questions Addressed in the Report on the Ethylene Dibromide Manufacturing Project:
How has the performance of the ethylene dibromide market been thus far, and what can be expected in the upcoming years?
What is the market segmentation of the global ethylene dibromide market?
What is the regional distribution of the global ethylene dibromide market?
What are the price trends of various feedstocks in the ethylene dibromide industry?
What is the structure of the Ethylene dibromide industry, and who are the major players?
What are the different unit operations involved in the manufacturing of ethylene dibromide?
What is the total land area required for the establishment of an ethylene dibromide manufacturing plant?
What is the layout of an ethylene dibromide manufacturing plant?
What are the machinery requirements for establishing an ethylene dibromide manufacturing plant?
What are the raw material requirements for setting up an ethylene dibromide manufacturing plant?
What are the packaging requirements for establishing an ethylene dibromide manufacturing plant?
What are the transportation requirements for establishing an ethylene dibromide manufacturing plant?
What are the utility requirements for establishing an ethylene dibromide manufacturing plant?
What are the human resource requirements for establishing an ethylene dibromide manufacturing plant?
What are the infrastructure costs associated with establishing an ethylene dibromide manufacturing plant?
What are the capital costs involved in setting up an ethylene dibromide manufacturing plant?
What are the operating costs associated with establishing an ethylene dibromide manufacturing plant?
What should be the pricing mechanism for the final product?
What will be the income and expenditures for an ethylene dibromide manufacturing plant?
What is the timeframe required to achieve the break-even point?
What are the profit projections for establishing an ethylene dibromide manufacturing plant?
What are the key factors for success and risks in the ethylene dibromide industry?
What are the essential regulatory procedures and requirements for establishing an ethylene dibromide manufacturing plant?
What are the necessary certifications required for establishing an ethylene dibromide manufacturing plant?
Explore Additional Reports by Syndicated Analytics:
Barbed Wire Manufacturing Plant Project Report: https://www.syndicatedanalytics.com/barbed-wire-manufacturing-plant-project-report
Detergent Cake Manufacturing Plant Project Report: https://www.syndicatedanalytics.com/detergent-cake-manufacturing-plant-project-report
Non Woven Bag Manufacturing Plant Project Report: https://www.syndicatedanalytics.com/non-woven-bag-manufacturing-plant-project-report
Glass Mirror Manufacturing Plant Project Report: https://www.syndicatedanalytics.com/glass-mirror-manufacturing-plant-project-report
Lubricant Manufacturing Plant Project Report: https://www.syndicatedanalytics.com/lubricant-manufacturing-plant-project-report
Surgical Bandage Manufacturing Plant Project Report: https://www.syndicatedanalytics.com/surgical-bandage-manufacturing-plant-project-report
Battery Water Manufacturing Plant Project Report: https://www.syndicatedanalytics.com/battery-water-manufacturing-plant-project-report
Our Distinctive Approach at Syndicated Analytics:
We offer a suite of services that provide comprehensive coverage of global markets, including a market snapshot and regional coverage. We understand the importance of customization and offer tailored reports to meet your individual scope or regional requirements.
Our research team utilizes exhaustive primary research methodologies, including collaboration with industry players, to gather accurate and reliable information. Additionally, we employ multiple waves of secondary desk-based research to provide a deep understanding of the market. Our analysts cross-validate the findings to ensure the data's accuracy and validity.
To provide impactful insights for our clients, we have a vast collection of research databases and data repositories. This allows us to draw from a wealth of information to create the most relevant and up-to-date insights. We are committed to providing high-quality research services to drive our clients' success.
Contact Info:
Katherine Shields
Senior Sales & Marketing Manager
134 N 4th St. Brooklyn,
NY 11249, USA
Phone No: +1-213-316-7435
Website: https://www.syndicatedanalytics.com/
Email Address: sales@syndicatedanalytics.com
About Us:
Syndicated Analytics, a subsidiary of IMARC Group, offers consulting services and provides comprehensive market intelligence in the form of research reports, production cost reports, and feasibility studies. Our team, consisting of experienced researchers and analysts from diverse industries, is deeply committed to the quality of the information and insights delivered to the clients, which range from small and medium enterprises to Fortune 1000 companies. These firms are able to achieve this by studying the qualitative and quantitative aspects of the market as well as staying up to date with the current and evolving trends of the industry.
This release was published on openPR.
Permanent link to this press release:
Copy
Please set a link in the press area of your homepage to this press release on openPR. openPR disclaims liability for any content contained in this release.
You can edit or delete your press release Project Report on Ethylene Dibromide Manufacturing Plant: Business Strategy, Equipment Needs, and Cost Breakdown here
News-ID: 3229934 • Views: …
More Releases from Syndicated Analystics
Eyeliner Manufacturing Plant Project Report: Manufacturing Process, Raw Material …
Syndicated Analytics' latest report titled "Eyeliner Manufacturing Plant Project Report 2024: Industry Analysis (Market Performance, Segments, Price Analysis, Outlook), Detailed Process Flow (Product Overview, Unit Operations, Raw Materials, Quality Assurance), Requirements and Cost (Machinery, Raw Materials, Packaging, Transportation, Utility, Human Resource), Project Economics (Capital Investments, Operating Costs, Profit Projections, Financial Analysis, Revenue), and Investment Opportunities" covers all the aspects including industry performance, key success, and risk factors, manufacturing requirements, project costs, and…
Carbon Disulfide Manufacturing Plant Project Report 2024: Business Plan, Cost An …
Syndicated Analytics' latest report, titled "Carbon Disulfide Manufacturing Plant Project Report 2024: Industry Analysis (Market Performance, Segments, Price Analysis, Outlook), Detailed Process Flow (Product Overview, Unit Operations, Raw Materials, Quality Assurance), Requirements and Cost (Machinery, Raw Materials, Packaging, Transportation, Utility, Human Resource), Project Economics (Capital Investments, Operating Costs, Profit Projections, Financial Analysis, Revenue), and Investment Opportunities," provides comprehensive insights for establishing a carbon disulfide manufacturing plant. The report covers industry performance, key success factors, risk factors,…
Orange Marmalade Manufacturing Plant Project Report 2024: Business Plan, Cost An …
Syndicated Analytics' latest report titled "Orange Marmalade Manufacturing Plant Project Report 2024: Industry Analysis (Market Performance, Segments, Price Analysis, Outlook), Detailed Process Flow (Product Overview, Unit Operations, Raw Materials, Quality Assurance), Requirements and Cost ( Machinery, Raw Materials, Packaging, Transportation, Utility, Human Resource), Project Economics (Capital Investments, Operating Costs, Profit Projections, Financial Analysis, Revenue), and Investment Opportunities," covers all the aspects including industry performance, key success, and risk factors, manufacturing requirements, project…
Polybutylene Adipate Terephthalate Manufacturing Plant Project Report: Raw Mater …
Syndicated Analytics' latest report, titled "Polybutylene Adipate Terephthalate Manufacturing Plant Project Report: Industry Trends, Manufacturing Process, Plant Setup, Machinery, Raw Materials, Investment Opportunities, Cost and Revenue (2023 Edition)," provides comprehensive insights for establishing a polybutylene adipate terephthalate manufacturing plant. The report covers industry performance, key success factors, risk factors, manufacturing requirements, project costs and economics, expected ROI, and profit margins. It combines desk research and qualitative primary research, making it…
More Releases for Project
Omega Project Review: Omega Project Honest Review: Omega Project
Omega Project Review: Is Aidan Booth's Course Worth Your Investment?
In the ever-evolving landscape of online business and digital marketing, finding a course that truly delivers on its promises can be a daunting task. One name that frequently pops up in discussions is Aidan Booth, a seasoned entrepreneur known for his innovative approaches to online marketing. His latest venture, The Omega Project, has garnered significant attention. But does it live up…
Merlin Project Version 9: AI-Powered Project Planning
Melle, Germany - December 12, 2024 - To mark its 20th anniversary, ProjectWizards is releasing Merlin Project 9, the latest version of its project management software. The standout feature is an AI assistant that automatically generates project plans from a simple text description. Tasks, phases, dependencies, workloads, milestones, and risks are instantly organized into a Gantt chart.
Quote from Frank Blome, CEO of ProjectWizards:
"We thank everyone who has supported us…
CCECCK Engineering Construction Bahrain Company road project contracting, railwa …
CCECCK Engineering Construction Bahrain Company https://adjustablewholesale.com/ is a leading engineering and construction company based in Bahrain, specialized in a wide range of engineering projects. We have expertise in road project contracting, railway engineering contracting, port project contracting, real estate project contracting, hospital project contracting, cultural center project contracting, shopping mall project contracting, and contracting of public facilities projects.
With over a decade of experience in the industry, we have a proven…
CCECCK Engineering Construction UAE Company road project contracting, railway en …
CCECCK Engineering Construction UAE Company https://oberlodropship.com/ is a leading engineering and construction company based in United Arab Emirates, specialized in a wide range of engineering projects. We have expertise in road project contracting, railway engineering contracting, port project contracting, real estate project contracting, hospital project contracting, cultural center project contracting, shopping mall project contracting, and contracting of public facilities projects.
With over a decade of experience in the industry, we have…
T-PPM Project Management new project dashboards
T-PPM - Project Portfolio Management (https://www.t-ppm.it) is a web solution that allows you to organize, manage and plan projects and the team. T-PPM is simple and intuitive to configure and use. In the new video we have created and published we show all the features and potential of dashboards. The features are available at different levels depending on the profiling role: Project Managers or actor who make up the project…
Engineering Project Consultant | Software Development Project
Pdgindia provide android training in pune India and also provides Corporate training in Android,Web Designing,Website Development,IEEE Project Development.
Project Development Group was set up in 2012 with an aim to establish itself among leading Global Project Providers. On road to the vision, the company has already emerged among India's fastest growing organizations that provide quality projects along with complete project guidance and training. The company motto "Your Destination For Perfection" reflects…